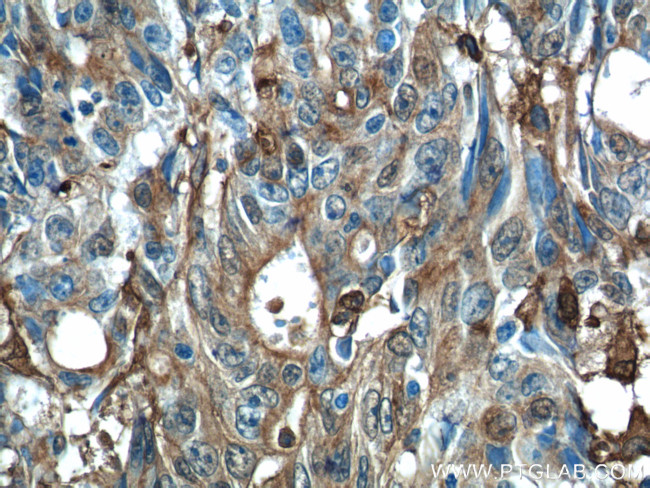
Gelsolin Antibody in Immunohistochemistry (Paraffin) (IHC (P))

Search
Proteintech
Gelsolin Polyclonal Antibody
{{$productOrderCtrl.translations['antibody.pdp.commerceCard.promotion.promotions']}}
{{$productOrderCtrl.translations['antibody.pdp.commerceCard.promotion.viewpromo']}}
{{$productOrderCtrl.translations['antibody.pdp.commerceCard.promotion.promocode']}}: {{promo.promoCode}} {{promo.promoTitle}} {{promo.promoDescription}}. {{$productOrderCtrl.translations['antibody.pdp.commerceCard.promotion.learnmore']}}
产品信息
11644-2-AP
种属反应
已发表种属
宿主/亚型
分类
类型
抗原
偶联物
形式
浓度
规格
纯化类型
保存液
内含物
保存条件
运输条件
产品详细信息
Immunogen sequence: MAAQHGMDD DGTGQKQIWR IEGSNKVPVD PATYGQFYGG DSYIILYNYR HGGRQGQIIY NWQGAQSTQD EVAASAILTA QLDEELGGTP VQSRVVQGKE PAHLMSLFGG KPMIIYKGGT SREGGQTAPA STRLFQVRAN SAGATRAVEV LPKAGALNSN DAFVLKTPSA AYLWVGTGAS EAEKTGAQEL LRVLRAQPVQ VAEGSEPDGF WEALGGKAAY RTSPRLKDKK MDAHPPRLFA CSNKIGRFVI EEVPGELMQE DLATDDVMLL DTWDQVFVWV GKDSQEEEKT EALTSAKRYI ETDPANRDRR TPITVVKQGF EPPSFVGWFL GWDDDYWSVD PLDRAMAELA A (433-782 aa encoded by BC026033)
靶标信息
The protein encoded by this gene binds to the "plus" ends of actin monomers and filaments to prevent monomer exchange. The encoded calcium-regulated protein functions in both assembly and disassembly of actin filaments. Defects in this gene are a cause of familial amyloidosis Finnish type (FAF). Multiple transcript variants encoding several different isoforms have been found for this gene.
仅用于科研。不用于诊断过程。未经明确授权不得转售。
生物信息学
蛋白别名: Actin-depolymerizing factor; ADF; ADFBrevin; AGEL; Brevin; DKFZp313L0718; epididymis secretory sperm binding protein; Gelsolin; RP11-477J21.1; unnamed protein product
基因别名: ADF; AGEL; AMYLD4; Gsb; GSN
UniProt ID: (Human) P06396, (Rat) Q68FP1, (Mouse) P13020
Entrez Gene ID: (Human) 2934, (Rat) 296654, (Mouse) 227753